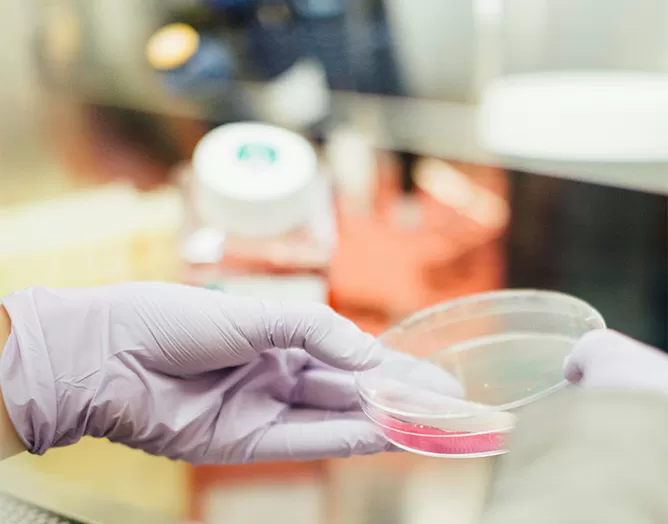
How It Works

At GCP ClinPlus, we provide comprehensive consulting services that cover the full clinical development lifecycle in China. Our offerings include regulatory pathway analysis, clinical study and protocol design, medical and scientific advisory, site selection and feasibility, clinical project management, and registration strategy. We also advise on commercialization planning to ensure long-term market success. Whether you're conducting bridging studies, initiating first-in-human trials, or preparing for NDA submission, our team of regulatory specialists, medical experts, and operational leaders deliver integrated, actionable solutions to de-risk your development and accelerate market access. With over 22 years of experience and proven success across therapeutic areas, we support clients from strategy to execution—every step of the way.
22+ years of experience in China clinical development
2200+ clinical studies and 210 regulatory approvals (NMPA, FDA, EMA)
Deep expertise in oncology, CGT, neuroscience, ophthalmology, MedTech and other key areas.
Proven track record with global companies including Abbott, Johnson & Johnson, Ionis, Bausch + Lomb, Santen, MicroPort and others.
In-house experts across medical, regulatory, and clinical operations.
Local insight + global standards for quality and compliance.
Initial Consultation:
We assess your goals, timeline, and target indication(s)
Customized Strategy:
We develop a tailored plan for regulatory, clinical, and operational execution

Execution Support:
We assist with design, approvals, and site management
Ongoing Advisory:
We provide real-time guidance through study conduct, registration, and commercialization
GCP ClinPlus delivers exceptional expertise with genuine commitment to our projects. Their team demonstrates remarkable responsibility at every stage, consistently going above and beyond. In an industry where dedication matters, they've proven themselves an invaluable partner for our success.
After enrollment challenges with our previous CRO threatened our study timeline, GCP ClinPlus stepped in and transformed our project. Their team rapidly accelerated patient recruitment beyond our expectations and put our critical study back on track. Their clinical expertise and swift implementation proved decisive in securing our study's success.
GCP ClinPlus stands out for their exceptional responsiveness and customer focus. Their team consistently prioritizes our needs with prompt, thoughtful solutions to every challenge. Their combination of technical excellence and client-centered approach makes them a truly strategic partner in our development programs.